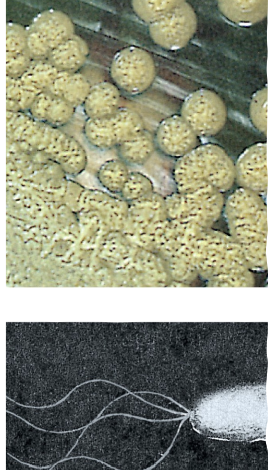
<p><strong>Rods or curved rods with polar flagellae.</strong></p>
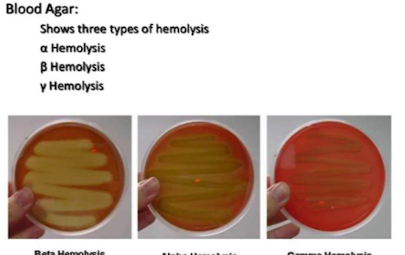
<img src="https://knowt-user-attachments.s3.amazonaws.com/8602ed2f-2f7d-4406-abad-5e0ce76685ed.png" data-width="25%" data-align="center"><p><strong>Alpha-haemolysis (α)</strong></p><ul><li><p><strong>Partial</strong> RBC breakdown → <strong>green zone</strong> on blood agar.</p></li><li><p>Caused by oxidation of haemoglobin</p></li></ul><p><strong>Beta-haemolysis (β)</strong></p><ul><li><p><strong>Complete</strong> RBC lysis → <strong>clear zone</strong> on blood agar.</p></li><li><p>Caused by haemolysins <strong>Streptolysin O and S</strong>.<strong><mark data-color="green" style="background-color: green; color: inherit;"> e.g. by </mark><em><mark data-color="green" style="background-color: green; color: inherit;">S. pyogenes</mark></em></strong></p></li></ul><p>Can also be classified by <strong>Lancefield groups</strong></p><p><strong>(immunological groups from A-O)</strong></p><p></p>

1/67
Flashcards covering the characteristics, metabolic diversity, and specific genera of Proteobacteria, including their roles in various environments and the human gut.
Name | Mastery | Learn | Test | Matching | Spaced |
|---|
No study sessions yet.
Which phylum is the largest among the bacterial lineages?
The Proteobacteria.

What is a defining characteristic of all Proteobacteria?
All Proteobacteria are Gram-negative.
Show extreme metabolic diversity
Represent the majority of GN bacteria which are of Medical, industrial, and agricultural significance.
Define 'phototrophic' as it relates to bacteria.
Uses energy from sunlight to convert CO2 into organic compounds.
Define 'chemolithotrophic' as it relates to bacteria.
Uses inorganic compounds such as H2S as their energy source.
Define 'chemoorganotrophic' as it relates to bacteria.
Uses organic compounds as their energy source.
What are the five major subdivisions of Proteobacteria?
Alpha (α), Beta (β), Gamma (γ), Delta (δ), and Epsilon (ε).
What are two examples of metabolic activities displayed by Proteobacteria related to sulfur and nitrogen?
Sulfur and Iron oxidizing bacteria
Nitrogen Fixing Bacteria
Sulfate and Sulphur reducing bacteria.
What genera do purple photosynthetic bacteria fall into?
alpha, beta or gamma proteobacteria
Such as genera Rhodospirillum, Rhodobacter, and Chromatium.

What do purple phototrophic bacteria use for anoxygenic photosynthesis?
Bacteriochlorophylls and carotenoids.
These pigments allow them to absorb light energy for photosynthesis without producing oxygen + UV protection

Where are these pigments in purple phototrophic bacteria found?
In the intracytoplasmic membranes within invaginations
Pigment levels increased when light decreases.

What is the electron donor used by Purple Sulfur Bacteria for CO2 reduction?
H2S.
Where are purple sulfur bactria found and their associated genera?
In stratified sulfur-rich lakes and hot springs; associated genera include Amoebobacter purpureus, Chromatium, Thiocystis

How do Purple Nonsulfur Bacteria differ from Purple Sulfur Bacteria in terms of sulfur usage and primary metabolic type?
They DO use sulfur BUT at much lower levels and are primarily photoheterotrophs.
What are examples of the morphological diversity of purple Nonsulfur bacteria?
They exhibit various forms such as rods, cocci, and spirals, with some being filamentous or forming clusters.
• Phaesospirillum fulvum
• Rhodopila globiformis

What type of metabolism do Nitrifying Bacteria exhibit?
Chemolithotrophic bacteria that oxidize ammonia or nitrite to obtain energy.

Which two groups comprise nitrifying bacteria, responsible for nitrogen cycle processes?
Nitrosifyers and Nitrifyers:
Phylum Nitrospira
What are examples of nitrosifying and nitrifying bacteria?
• Nitrosococcus oceani
– Nitrosifying
• Nitrobacter winogradskyi
– Nitrifying
Invaginations in membranes allow for increased surface area and facilitate the enzymes involved in nitrogen oxidation, promoting efficient conversion of ammonia into nitrate.


Describe the typical colony morphology and flagellation of Pseudomonads.
Rods or curved rods with polar flagellae.
What metabolic pathway do Pseudomonads use for glucose metabolism?
The Entner-Doudoroff pathway

Name two diseases caused by species of Neisseria.
Meningitis and gonorrhea.
What form are Neisseria?
They are typically spherical, gram-negative diplococci.

List four genera of enteric bacteria.
Escherichia
Shigella
Salmonella
Proteus.
Where is the enteric bacteria Escherichia found?
Gastrointestinal tract (very low levels unless dysbiosis has occured), most commensal but many pathogenic forms
What are some features of the enteric bacteria Shigella?
Very closely related to Escherichia genera, and pathogenic i.e Shigella toxin that disrupts protein synthesis, leading to cell death.
They are primarily responsible for bacillary dysentery and are transmitted via the fecal-oral route.
Is Proteus urease positive?
Yes, Proteus is urease positive, producing urease enzyme that hydrolyzes urea to ammonia, increasing pH.
What mechanism do Vibrio and Photobacterium use to regulate gene expression based on cell-population density?
Quorum sensing using HSL (homoserine lactones) to communicate with neighboring cells.

What enzyme is related with bioluminescence in Vibrio cholera?
Luciferase is responsible for bioluminescence in Vibrio cholera.
It catalyzes the oxidation of luciferin, producing light.
What is Rickettsia's characteristic mode of existence?
Obligate intracellular parasites e.g Rickettsiella popilliae
How are Rickettsia generally transferred to hosts?
By arthropods such as Pyronota setosa
Larva of P. setosa showing milky translucent symptoms
and subcuticular melanized spots typical of Rickettsiella infection

What is different about Rochalimaea compared to other obligate intracellular parasites in Rickettsias?
Can survive outside of host cells and be grown in culture, unlike many other Rickettsias.
Responsible for Trench fever in WW1
What is the Spirilla species?
Gram-negative, motile spiral-shaped Proteobacteria that show a wide variety of physiological attributes.
• Spirillum, Bdellovibrio, Campylobacter, Helicobacter

Which genus of Spirilla is known as a "bacterial predator"?
Bdellovibrio e.g Bdellovibrio bacteriavorus
• Progeny depend on size of the host cell.
Attach to host prey
Penetrate them forming a prey periplasmic space
Elongate inside the bdelloplast
Lyse the prey’s cell to reproduce and release new bdellovibrios.

Which group in Spirilla are Campylobacter and Helicobacter in?
Epsilon group
What diseases are associated with Campylobacter jejuni and Helicobacter pylori?
Campylobacter jejuni causes gastroenteritis
Helicobacter pylori causes gastritis, duodenal ulcers, and gastric cancer, clincial manifestations are not always evident and infection can lead to chronic conditions.

What is a defining characteristic and survival mechanism of Sheathed Proteobacteria like Sphaerotilus natans?
They grow in long sheaths which they can leave under unfavorable conditions to disperse.

Describe the unique reproductive process of Budding and Stalked bacteria.
They form cytoplasmic extrusions from which new daughter cells evolve.
e.g Hyphomicrobium cell cycle results in new daughter cell.

What unique structures and behavior characterize Gliding Myxobacteria?
They glide on surfaces, form fruiting bodies, and have a complex lifecycle including myxospores.
e.g Myxococcus Xanthus
Chondromyces crocatus

What is the human gut microbiome?
• Predominantly Firmicutes and Bacteroides found in the human gut.
• Approximately 1000 species present with 150x number of genes found in the host.
• A huge repertoire of genes which can play a role in digestion, vitamin production etc.
• Stability of Microbiome critical.
What percentage of bacteria in a healthy human gut are typically Proteobacteria?
Approximately 4.5%, low as most GN proteobacteria cause disease and are not predominant in gut flora.
What term describes an increase in Proteobacteria in the human gut, often associated with disease?
Proteobacterial bloom or dysbiosis.

Why is the stability of the human gut microbiome considered critical?
It plays a huge role in digestion, vitamin production, and overall host health, and a disturbed balance (dysbiosis) can lead to disease.
What are phyla 2 and 3 of GP bacteria?
Phylum 2: Low GC content bacteria or Firmicutes
Phylum 3: High GC content bacteria or Actinobacteriae
what is meant by GC content?
GC content refers to the percentage of guanine (G) and cytosine (C) nucleotides in a DNA molecule, which can influence the stability and structure of the genome.
What are common genera and traits of non-sporulating, low GC Gram +ve bacteria?
(Phyl 2)Common genera include Lactobacillus, Streptococcus,Staphylococcus, and Listeria which are involved in fermentation, food production, and human health.
Whar are Staphylococci known for?

Staphylococci are common commensals although S. aureus is a major problem in
hospital acquired infections (MRSA)
• Coccoid cells in clusters, catalase positive, gives them more resilience against ROS
Whar are Streptococci known for?
• Some members pathogenic to humans
• Others have role in dairy industry (buttermilk and silage)
• Chains of cells.

How are streptococci classified by α- and β-haemolysis on blood agar?

Alpha-haemolysis (α)
Partial RBC breakdown → green zone on blood agar.
Caused by oxidation of haemoglobin
Beta-haemolysis (β)
Complete RBC lysis → clear zone on blood agar.
Caused by haemolysins Streptolysin O and S. e.g. by S. pyogenes
Can also be classified by Lancefield groups
(immunological groups from A-O)
What are Lactobacillus known for?
• Rod shaped
• Common in dairy products
• Survive at low pH so usually can finish a
fermentation.
• Rarely if ever pathogenic
e.g. Lactobacillus delbrueckii.
Listeria
• GP cocco-bacilli forming short chains
• Catalase positive and requires aerobic conditions to grow
What disease is caused by Listeria monocytogenes?
Listeriosis (high mortality despite low incidence)
Facultative anaerobic, catalase positive cocco-bacillus
Sporulating, Low GC Gram-Positive Bacteria
Bacillus and Clostridium
Key traits of Bacillus?
Low GC, GP Aerobic rods, spore-formers
Some produce antibiotics (bacitracin, polymyxin)
Pathogen: B. anthracis (anthrax)
B. thuringiensis → Bt toxin (insecticidal)
Key traits of Clostridia?
Anaerobic; no cytochromes
ATP via substrate-level phosphorylation
Lives in anoxic soil/intestinal pockets
Includes C. botulinum, C. tetani, C. perfringens, C. difficile
What are Mycoplasmas?
No Cell Wall, Low GC Gram-Positive Bacteria
Lack of a cell wall means a lack of rigidity so sterols in membranes
Smallest genomes able to replicate independently
Require rich media
High GC Gram-Positive Bacteria (Actinobacteria)
Corynebacterium, Arthrobacter, Propionibacterium, Mycobacterium
Mostly commensal aerobic rod-filamentous bacteria in soil
Mycobacterium notable pathogenic exception
Important for antibiotic & dairy fermentation e.g. (propionibacterium and Emmental).
What characterises filamentous Actinobacteria?
Streptomyces form branching mycelia
Produce majority of natural antibiotics
What is phylum 4?
Cyanobacteria
Why are cyanobacteria important evolutionarily?
• One of the major phyla of the domain
• A large and heterogenous group of bacteria
• Phototrophic bacteria
• Thought to have converted the earth from anoxic to oxic (the stromatolites)
• Contain chlorophyll A and phycobilins ( light capturing bilins )
• Also include Prochlorophytes which have chlorphyll A+B.
Examples of morphological diversity in cyanobacteria?
Gloeothece: unicellular
Fischerella: filamentous & branching
What are heterocysts?
Specialized cells in Anabaena for nitrogen fixation
Protect nitrogenase from oxygen
Gas vesicles provide buoyancy

What are key traits of Chlamydia (phylum 5)?
Obligate intracellular parasites
Limited metabolic capacity
Lacks ftsZ (cell division gene)
Contains some eukaryote-like genes
Which diseases are caused by Chlamydia species?
C. trachomatis: STD, trachoma
C. psittaci: psittacosis
C. pneumoniae: respiratory disease
What are the two life-cycle forms of Chlamydia?
Elementary bodies (infectious, non-growing)
Reticulate bodies (replicating, non-infectious)
Replication cycle ~2–3 hours

What defines spirochetes?
Helical, tightly coiled bacteria
“Gram-negative-like”
Aquatic habitats; 8 genera
Characterised by their flexible cell wall, which allows them to move in a corkscrew motion.
Known for causing diseases such as Lyme disease and syphilis.
Which important diseases are caused by spirochetes?
Treponema → syphilis
Borrelia → Lyme disease, relapsing fever
Leptospira → leptospirosis
What is special about Deinococcus radiodurans?
Extremely radiation resistant
Efficient DNA repair, multiple repair enzymes
Toroidal DNA formation
What is Thermus known for?
Thermus aquaticus (source of Taq polymerase) is known for its ability to thrive in high-temperature environments, making it essential in molecular biology for PCR amplification due to its heat-stable enzymes.
What other phyla of bacteria has a role in the gut microbiome?
Flavobacteria: Bacteroides